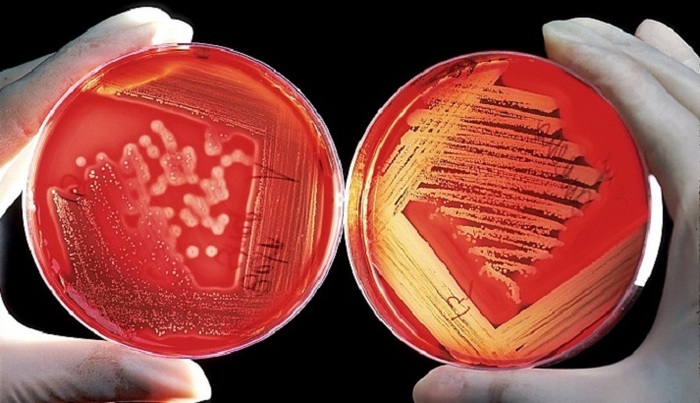
В Европе стремительно распространяется устойчивый «супергрибок» Trichophyton indotineae - фото

В ряде европейских стран фиксируется быстрое распространение опасного грибка Trichophyton indotineae, отличающегося высокой устойчивостью к лечению. Об этом сообщает The Sun, отмечая, что в медицине его уже называют «супергрибком».
Эксперт по инфекционным заболеваниям Манчестерского университета Дэвид Деннинг пояснил, что инфекция проявляется в виде красных зудящих высыпаний, которые чаще всего возникают в области паха, на бедрах и ягодицах.
По данным издания, в Великобритании за последние три года количество подтвержденных случаев заражения выросло почти на 500%. Грибок передается при прямом контакте с больным человеком, через зараженные предметы и поверхности, а также может распространяться половым путем.
Деннинг подчеркнул, что дальнейшее распространение Trichophyton indotineae способно превратиться в серьезную глобальную проблему, учитывая его устойчивость и скорость передачи.
Вера Сергеева.
Фото: Pixabay.com















